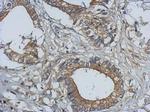
Bcl-10 Antibody in Immunohistochemistry (Paraffin) (IHC (P))

Search
Invitrogen
Bcl-10 Polyclonal Antibody
{{$productOrderCtrl.translations['antibody.pdp.commerceCard.promotion.promotions']}}
{{$productOrderCtrl.translations['antibody.pdp.commerceCard.promotion.viewpromo']}}
{{$productOrderCtrl.translations['antibody.pdp.commerceCard.promotion.promocode']}}: {{promo.promoCode}} {{promo.promoTitle}} {{promo.promoDescription}}. {{$productOrderCtrl.translations['antibody.pdp.commerceCard.promotion.learnmore']}}
图: 1 / 7
Bcl-10 Antibody (PA5-34800) in ICC/IF

产品信息
PA5-34800
种属反应
宿主/亚型
分类
类型
抗原
偶联物
形式
浓度
规格
纯化类型
保存液
内含物
保存条件
运输条件
RRID
产品详细信息
Recommended positive controls: HeLa, Raji, Neuro2A, GL261, C8D30.
Predicted reactivity: Mouse (91%), Rat (92%), Pig (92%), Rhesus Monkey (99%), Bovine (95%).
Store product as a concentrated solution. Centrifuge briefly prior to opening the vial.
靶标信息
BCL-10 is an N-terminal CARD (Caspase Recruitment Domain) containing protein that is involved in the adaptive immune response. It promotes apoptosis, pro-caspase-9 maturation, and activation of NF-kappa-B via NIK and IKK. BCL-10 is also an adapter protein between upstream TNFR1-TRADD-RIP complex and the downstream NIK-IKK-IKAP complex. It is a substrate for MALT1. Mutations in the gene can lead to Immmunodeficiency 37 or Lymphoma, mucosa-associated lymphoid type.
⚠WARNING: This product can expose you to chemicals including mercury, which is known to the State of California to cause birth defects or other reproductive harm. For more information go to www.P65Warnings.ca.gov.
仅用于科研。不用于诊断过程。未经明确授权不得转售。
篇参考文献 (0)
生物信息学
蛋白别名: B cell CLL/lymphoma 10; B-cell CLL/lymphoma 10; B-cell leukemia/lymphoma 10; B-cell lymphoma/leukemia 10; Bcl-10; c-E10; CARD containing molecule enhancing NF-kB; CARD-containing apoptotic signaling protein; CARD-containing molecule enhancing NF-kappa-B; CARD-containing proapoptotic protein; CARD-like apoptotic protein; CARMEN; caspase-recruiting domain-containing protein; cCARMEN; CED-3/ICH-1 prodomain homologous E10-like regulator; Cellular homolog of vCARMEN; Cellular-E10; CIPER; hCLAP; Mamm; Mammalian CARD-containing adapter molecule E10; mCIPER; mCLAP; mE10; OTTHUMP00000011647; OTTHUMP00000036080; protein binding; signal transducer activity; RP11-234D19.2; unnamed protein product
基因别名: AI132454; BCL-10; BCL10; c-E10; C81403; CARMEN; cE10; CIPER; CLAP; IMD37; ME10
UniProt ID: (Human) O95999, (Mouse) Q9Z0H7
Entrez Gene ID: (Human) 8915, (Mouse) 12042



